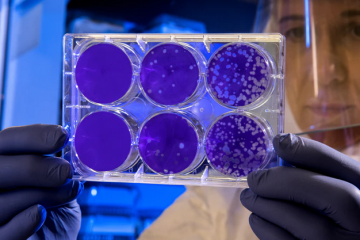

Enerji Bakanından Elektrik Faturaları ile Alakalı Korona Açıklaması
Salgın hastalık ilan edilen korona virüsün yeni versiyonu Covid-19 ile birlikte vakalar ve ölüm sayıları ülkemizde de yavaş yavaş artmaya başladı. Bundan korunmanın en iyi yolu olan insanlarla irtibatı kesme işlemi için kamu ve özel kuruluşlar ellerinden geldiğince çaba gösteriyor. Enerji ve Tabii Kaynaklar Bakanı Fatih Dönmez tarafından bugün yapılan Devamı